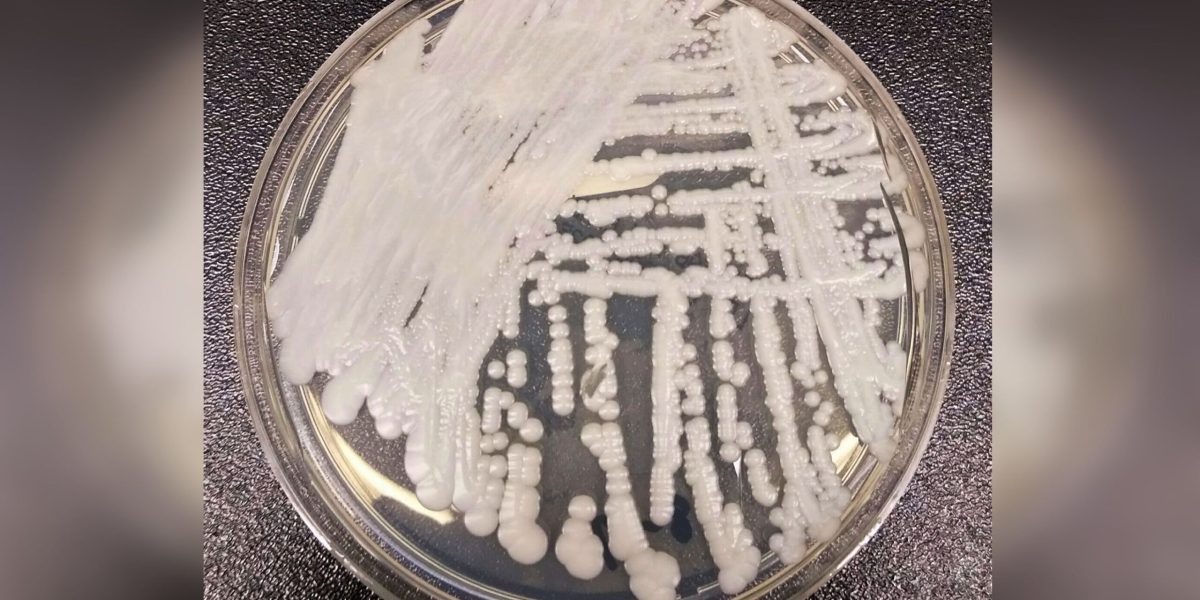
Candida auris, coșmarul spitalelor, endemică și în România

Ciuperca Candida auris, o infecție fungică periculoasă, a devenit endemică în cinci țări europene, inclusiv România, potrivit unei noi analize. Studiul, publicat recent, clasifică Italia, Spania, Grecia, România și Regatul Unit ca zone în care răspândirea agentului patogen este susținută în unitățile medicale. Această situație îngreunează distincția între focarele izolate și prezența continuă a infecției.
Răspândirea accelerată în Europa
Între 2013 și 2023, autoritățile sanitare europene au raportat peste 4.000 de cazuri de colonizare sau infecție cu Candida auris. O creștere dramatică a fost observată începând cu anul 2020. Ciuperca prezintă un risc major pentru pacienții cu stare critică și pentru cei imunocompromiși, adesea demonstrând rezistență la tratamentele antifungice standard, precum fluconazolul.
Nicholas Geremia, specialist în boli infecțioase din Veneția, a menționat că rezistența ciupercii la mediul spitalicesc face controlul infecției deosebit de dificil. Capacitatea agentului patogen de a supraviețui pe suprafețele din spitale și de a rezista la dezinfectanții obișnuiți reprezintă o amenințare constantă. Infecția a fost identificată pentru prima dată în Japonia în 2009. Factorii care au contribuit la răspândirea globală includ schimbările climatice și numărul crescut de pacienți vulnerabili în urma pandemiei de COVID-19.
Impactul asupra pacienților vulnerabili
Nelesh Govender, profesor la Universitatea din Witwatersrand, a avertizat asupra impactului sever asupra unităților de neonatologie. „Nou-născuții prematuri au bariere hematoencefalice atât de imature încât, atunci când C. auris pătrunde în fluxul sanguin, poate ajunge direct în creier,” a explicat acesta. În Africa de Sud, Candida auris a devenit a doua cauză principală de candidemie care pune viața în pericol.
Specialiștii subliniază importanța screeningului riguros și a cooperării multidisciplinare pentru gestionarea amenințării. Matteo Bassetti, director clinic la Spitalul Universitar San Martino din Genova, a raportat eliminarea cu succes a cazurilor de candidemie din unitatea sa până în 2024. Aceasta a fost realizată prin protocoale stricte de izolare și curățare.
Măsuri de control și tratament
Bassetti a subliniat că rata mortalității este comparabilă cu cea a altor specii de Candida, datorită existenței opțiunilor de tratament eficiente. El a atribuit succesul unei strategii de colaborare care a implicat specialiști, microbiologi și asistente medicale.
În ciuda provocărilor, există modalități de control a răspândirii Candida auris. Implementarea unor protocoale stricte de igienă și izolare în unitățile medicale este esențială. Cooperarea între diferiți specialiști medicali și monitorizarea constantă a pacienților vulnerabili pot contribui la limitarea impactului acestei infecții fungice periculoase.
Sursa: Go4IT